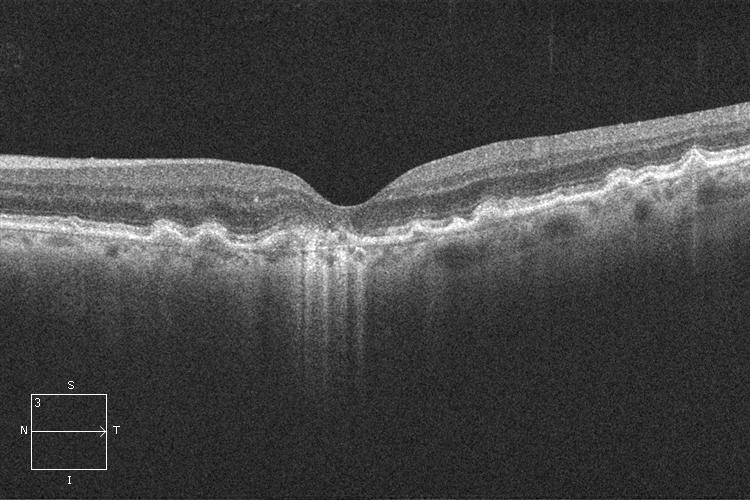
fullwidth image
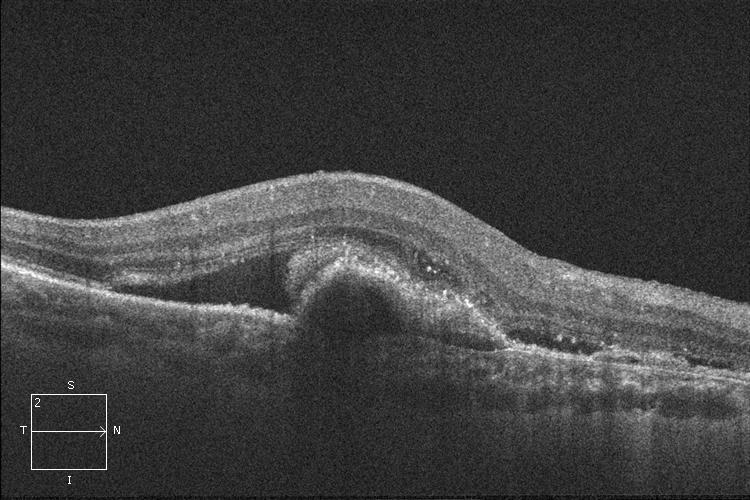
fullwidth image
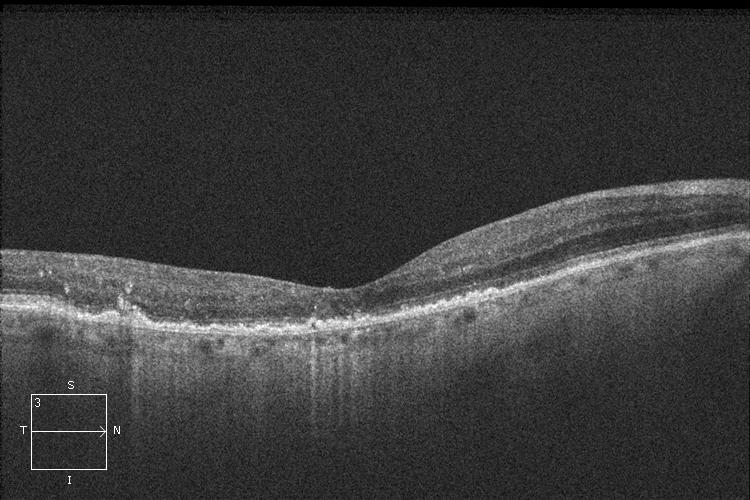
fullwidth image

Degeneración Macular Asociada a la Edad (DMAE)
¿Qué es la Degeneración Macular Asociada a la Edad (DMAE)?
La Degeneración Macular Asociada a la Edad (DMAE) es una enfermedad degenerativa caracterizada por una lesión en la parte central de la retina: la mácula. La mácula es la encargada de la visión central que permite distinguir detalles, reconocer las caras de las personas, leer, coser, ver la televisión, conducir o definir los colores. Los pacientes con Degeneración Macular Asociada a la Edad (DMAE) tienen alterada la visión central lo que representa un fuerte impacto en su vida cotidiana.
La Degeneración Macular Asociada a la Edad (DMAE) es la causa más frecuente de pérdida de visión en pacientes de más de 50 años en nuestro país.
La edad, el tabaco, la hipertensión arterial, exposición solar, sobrepeso y una predisposición genética son los principales factores de riesgo asociados a la Degeneración Macular Asociada a la Edad (DMAE).
¿Qué tipos de Degeneración Macular Asociada a la Edad (DMAE) existen?
- La Degeneración Macular Asociada a la Edad (DMAE) seca es la más frecuente. Se caracteriza por la aparición de depósitos, adelgazamiento y cambios de pigmentación en la mácula. Se manifiesta por una pérdida lenta y progresiva de la visión central.
- La Degeneración Macular Asociada a la Edad (DMAE) húmeda o exudativa es menos frecuente pero más agresiva. Se caracteriza por la aparición de vasos sanguíneos anómalos que crecen por debajo de la retina permitiendo el paso inadecuado de sangre y líquido. La mácula deja de funcionar correctamente y la visión se vuelve distorsionada y borrosa. Sin ningún tratamiento la pérdida de visión puede ser rápida y severa.

DMAE seca

DMAE húmeda o exudativa
¿Cómo se diagnostica la Degeneración Macular Asociada a la Edad (DMAE)?
- La Degeneración Macular Asociada a la Edad (DMAE) seca se diagnostica mediante la exploración del fondo del ojo bajo dilatación pupilar. Su estudio puede completarse con la realización de una tomografía de coherencia óptica (OCT) y autofluorescencia.
- La Degeneración Macular Asociada a la Edad (DMAE) húmeda o exudativa se diagnostica mediante la exploración del fondo del ojo bajo dilatación pupilar, la realización de una tomografía de coherencia óptica (OCT) y una angiografía fluoresceínica (AGF). Las 3 pruebas son complementarias y permiten conocer mejor el grado de DMAE húmeda para un enfoque terapéutico adecuado.
OCT. DMAE seca
OCT. DMAE húmeda o exudativa

Angiografía DMAE húmeda o exudativa
¿Cómo prevenir la Degeneración Macular Asociada a la Edad (DMAE)?
Se aconseja llevar un estilo de vida sano con una dieta equilibrada y realizar ejercicio de forma regular.
¿Cómo tratar la Degeneración Macular Asociada a la Edad (DMAE)?
La Degeneración Macular Asociada a la Edad (DMAE) seca no tiene tratamiento. El aporte de complejos multivitamínicos puede enlentecer su progresión en algunos casos.
La Degeneración Macular Asociada a la Edad (DMAE) húmeda o exudativa se trata con inyecciones intravítreas de fármacos antiangiogénicos. Suelen ser necesarias varias inyecciones antes de lograr controlar el crecimiento de los vasos sanguíneos responsables de la enfermedad. Las inyecciones intravítreas pueden realizarse en una sala limpia o quirófano, con anestesia local y en condiciones de esterilidad.

OCT. DMAE húmeda o exudativa antes del tratamiento con inyecciones intravítreas.
OCT. DMAE húmeda o exudativa después del tratamiento con inyecciones intravítreas.
Debería saber...
- La Degeneración Macular Asociada a la Edad (DMAE) afecta únicamente la visión central pero la visión periférica queda intacta. Es importante que el paciente sepa que la Degeneración Macular Asociada a la Edad (DMAE) no evoluciona hacia una “ceguera total”. La visión periférica permite al paciente conservar su autonomía, desplazarse sin ayuda, etc.
- El Test de Amsler es una prueba sencilla que permite detectar precozmente la aparición de una Degeneración Macular Asociada a la Edad (DMAE) exudativa.